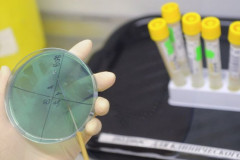

Միջազգային
 Աշխարհում պարենամթերքի ռեկորդային էժանացում է արձանագրվել
Աշխարհում պարենամթերքի ռեկորդային էժանացում է արձանագրվել
 Մոգերինին սիրիական հակամարտության ռազմական լուծման կողմնակից չէ
Մոգերինին սիրիական հակամարտության ռազմական լուծման կողմնակից չէ
 Դոնոր երկրները Սիրիայի համար հանգանակել են ավելի քան 10 միլիարդ դոլար
Դոնոր երկրները Սիրիայի համար հանգանակել են ավելի քան 10 միլիարդ դոլար
 Երկու մարդ վնասվածք է ստացել Ստամբուլում տեղի ունեցած պայթյունի հետեւանքով
Երկու մարդ վնասվածք է ստացել Ստամբուլում տեղի ունեցած պայթյունի հետեւանքով
 Եմենում ոչնչացվել է Ալ-Քաիդայի ղեկավարներից մեկը
Եմենում ոչնչացվել է Ալ-Քաիդայի ղեկավարներից մեկը
 Հունաստանում 24-ժամյա համընդհանուր գործադուլ է անցկացվում
Հունաստանում 24-ժամյա համընդհանուր գործադուլ է անցկացվում
 Եվրահանձնաժողովը կտրուկ նվազեցրել է նավթի գնի կանխատեսումը
Եվրահանձնաժողովը կտրուկ նվազեցրել է նավթի գնի կանխատեսումը
 ԵՄ-ն այս տարի 3 մլրդ եվրո կհատկացնի Սիրիայի հակամարտության հետեւանքների դեմ պայք...
ԵՄ-ն այս տարի 3 մլրդ եվրո կհատկացնի Սիրիայի հակամարտության հետեւանքների դեմ պայք...
 Իրանն ու Ռուսաստանը Կասպից ծովը միացնում են Պարսից ծոցին
Իրանն ու Ռուսաստանը Կասպից ծովը միացնում են Պարսից ծոցին
 Ադրբեջանի խորհրդարանը ՄԻԵԴ-ի որոշումները չկատարելու մասին օրինագիծ կքննարկի
Ադրբեջանի խորհրդարանը ՄԻԵԴ-ի որոշումները չկատարելու մասին օրինագիծ կքննարկի
 Իրանը կշարունակի զարգացնել իր հրթիռային ծրագիրը
Իրանը կշարունակի զարգացնել իր հրթիռային ծրագիրը
 ՄԻԵԴ-ը Ադրբեջանին պատժել է թալիշական թերթի խմբագրի իրավունքները խախտելու համար
ՄԻԵԴ-ը Ադրբեջանին պատժել է թալիշական թերթի խմբագրի իրավունքները խախտելու համար
 Սիրիական ճգնաժամի համար պատասխանատվությունը կրում Է միջազգային հանրությունը. Պան...
Սիրիական ճգնաժամի համար պատասխանատվությունը կրում Է միջազգային հանրությունը. Պան...
 Թուրքիան հետ է ուղարկել Վատիկանում իր դեսպանին
Թուրքիան հետ է ուղարկել Վատիկանում իր դեսպանին
 Թուրքիան մտադիր է պահանջել Իրանից իջեցնել գազի գինը
Թուրքիան մտադիր է պահանջել Իրանից իջեցնել գազի գինը
 ՄԱԿ-ը հանդես Է եկել Ասանժի պաշտպանությամբ
ՄԱԿ-ը հանդես Է եկել Ասանժի պաշտպանությամբ
 Գերմանիան երեք տարում 2,3 մլրդ եվրո կհատկացնի սիրիացի փախստականների կարիքների հա...
Գերմանիան երեք տարում 2,3 մլրդ եվրո կհատկացնի սիրիացի փախստականների կարիքների հա...
 Սիրիական հակամարտության լուծումը հնարավոր Է միայն նոր կառավարություն ընտրելու մի...
Սիրիական հակամարտության լուծումը հնարավոր Է միայն նոր կառավարություն ընտրելու մի...
 Լավրովը եւ Քերին պայմանավորվեցին կարճատեւ դարձնել միջսիրիական բանակցությունների ...
Լավրովը եւ Քերին պայմանավորվեցին կարճատեւ դարձնել միջսիրիական բանակցությունների ...
 Ահաբեկչական խմբավորումները հրթիռներ են արձակել Նոր գյուղի վրա
Ահաբեկչական խմբավորումները հրթիռներ են արձակել Նոր գյուղի վրա
 Shell-ը 10 հազար աշխատակիցների կկրճատի շահույթի ռեկորդային անկման պատճառով
Shell-ը 10 հազար աշխատակիցների կկրճատի շահույթի ռեկորդային անկման պատճառով
 ԱՄՆ-ն Իսրայելին 120 մլն դոլար կտրամադրի «Երկաթե գմբեթի» նմանակի ստեղծման համար
ԱՄՆ-ն Իսրայելին 120 մլն դոլար կտրամադրի «Երկաթե գմբեթի» նմանակի ստեղծման համար
 Քյոլնում ավանդական դիմակահանդեսն ընթանում Է անվտանգության ուժեղացված միջոցների պ...
Քյոլնում ավանդական դիմակահանդեսն ընթանում Է անվտանգության ուժեղացված միջոցների պ...
 BBC-ն ցուցադրել Է ՆԱՏՕ-ի եւ Ռուսաստանի հակամարտության հնարավոր սցենարը
BBC-ն ցուցադրել Է ՆԱՏՕ-ի եւ Ռուսաստանի հակամարտության հնարավոր սցենարը
 Աշխարհի ամենակոռումպացված երկրներից մեկը՝ Ադրբեջանը օգնության որոնումներում է. Q...
Աշխարհի ամենակոռումպացված երկրներից մեկը՝ Ադրբեջանը օգնության որոնումներում է. Q...
 Ասանժը չի բացառել, որ կարող Է փետրվարի 5-ին հանձնվել Մեծ Բրիտանիայի ոստիկանությանը
Ասանժը չի բացառել, որ կարող Է փետրվարի 5-ին հանձնվել Մեծ Բրիտանիայի ոստիկանությանը
 Մոսկվան չի մոռանա Թուրքիայի աջակցությունը ահաբեկիչներին. Լավրով
Մոսկվան չի մոռանա Թուրքիայի աջակցությունը ահաբեկիչներին. Լավրով
 Ֆլորիդայի նահանգի չորս օկրուգներում արտակարգ դրության ռեժիմ է հայտարարվել Զիկա տ...
Ֆլորիդայի նահանգի չորս օկրուգներում արտակարգ դրության ռեժիմ է հայտարարվել Զիկա տ...
 12 երկրներ ԱՄՆ-ի գլխավորությամբ առեւտրական դաշինքի համաձայնագիր են ստորագրել
12 երկրներ ԱՄՆ-ի գլխավորությամբ առեւտրական դաշինքի համաձայնագիր են ստորագրել
 Քլինթոնն ընտրություններում հաղթելու դեպքում զորք չի ուղարկի Իրաք ու Սիրիա
Քլինթոնն ընտրություններում հաղթելու դեպքում զորք չի ուղարկի Իրաք ու Սիրիա
 «Համահայկական ճակատ» կուսակցության դիրքորոշումները համընկնում են ԴՕԿ կուսակցության մոտեցումների հետ` հիմնված ազգային և պետական շահերի գերակայության վրա․ Արսեն Վարդանյան
«Համահայկական ճակատ» կուսակցության դիրքորոշումները համընկնում են ԴՕԿ կուսակցության մոտեցումների հետ` հիմնված ազգային և պետական շահերի գերակայության վրա․ Արսեն Վարդանյան Ուժեղ Հայաստանի Ուժեղ Հրազդանը. Նարեկ Կարապետյան
Ուժեղ Հայաստանի Ուժեղ Հրազդանը. Նարեկ Կարապետյան ՀՃԿ անդամ, ԶՈւ պահեստազորի փոխգնդապետ Նառա Գևորգյանի հարցազրույցից հատված
ՀՃԿ անդամ, ԶՈւ պահեստազորի փոխգնդապետ Նառա Գևորգյանի հարցազրույցից հատված Կան ուժեր, որոնք խթանում են 300,000 ադրբեջանցիների բնակեցումը Հայաստանում. մենք խթանում ենք 300,000 աշխատատեղ հայերի համար և փոփոխության հույս. Ուժեղ Հայաստան
Կան ուժեր, որոնք խթանում են 300,000 ադրբեջանցիների բնակեցումը Հայաստանում. մենք խթանում ենք 300,000 աշխատատեղ հայերի համար և փոփոխության հույս. Ուժեղ Հայաստան Ուժեղ Հայաստանի Ուժեղ Չարենցավանը․ Նարեկ Կարապետյան
Ուժեղ Հայաստանի Ուժեղ Չարենցավանը․ Նարեկ Կարապետյան Ինչպես են Նարեկ Կարապետյանին դիմավորում Չարենցավանում և Հրազդանում
Ինչպես են Նարեկ Կարապետյանին դիմավորում Չարենցավանում և Հրազդանում Փաշինյան, ի՞նչ ես արել երկրի համար, բացի քաղաքացիներին վիրավորելուց ու Հայաստան 300,000 ադրբեջանցիներ բերելու ծրագրին համաձայնություն տալուց. Նարեկ Կարապետյան
Փաշինյան, ի՞նչ ես արել երկրի համար, բացի քաղաքացիներին վիրավորելուց ու Հայաստան 300,000 ադրբեջանցիներ բերելու ծրագրին համաձայնություն տալուց. Նարեկ Կարապետյան «Ուժեղ Հայաստան»-ը գրասենյակ է բացել Չարենցավանում
«Ուժեղ Հայաստան»-ը գրասենյակ է բացել Չարենցավանում
 Երևան-Սևան-Իջևան ավտոճանապարհին «Mercedes»-ը դուրս է եկել ճանապարհի երթևեկելի գոտուց և մի քանի պտույտ գլխիվայր շրջվելով հայտնվել ձորում․ կան վիրшվորներ
Երևան-Սևան-Իջևան ավտոճանապարհին «Mercedes»-ը դուրս է եկել ճանապարհի երթևեկելի գոտուց և մի քանի պտույտ գլխիվայր շրջվելով հայտնվել ձորում․ կան վիրшվորներ Իրանի հետ բանակցությունները վերսկսելու համար ԱՄՆ-ն պետք է վերացնի բոլոր խոչընդոտները․ Փեզեշքիան
Իրանի հետ բանակցությունները վերսկսելու համար ԱՄՆ-ն պետք է վերացնի բոլոր խոչընդոտները․ Փեզեշքիան Աշխարհը չպետք է թույլ տա, որ Չեռնnբիլի шղետը կրկնվի․ դա անելու լավագույն միջոցը Ռուսաստանին uտիպելն է դադարեցնել իր խելագար հшրձակումները․ Զելենսկի
Աշխարհը չպետք է թույլ տա, որ Չեռնnբիլի шղետը կրկնվի․ դա անելու լավագույն միջոցը Ռուսաստանին uտիպելն է դադարեցնել իր խելագար հшրձակումները․ Զելենսկի Արդարադատության դեֆիցիտը մանկավարժականի դեպքերի հետ կապված․ Իրականությունն առանց դիմակի
Արդարադատության դեֆիցիտը մանկավարժականի դեպքերի հետ կապված․ Իրականությունն առանց դիմակի Մարտունիում բшխվել են «Nissan Xterra»-ն և «ՎԱԶ 2106»-ը․ կա վիրшվոր
Մարտունիում բшխվել են «Nissan Xterra»-ն և «ՎԱԶ 2106»-ը․ կա վիրшվոր
 Սա ոչ միայն մեծ պատիվ է մեր երկրի համար, այլև հայ մարզիկների տարիների աշխատանքի արժանի գնահատականը. Գագիկ Ծառուկյան
Սա ոչ միայն մեծ պատիվ է մեր երկրի համար, այլև հայ մարզիկների տարիների աշխատանքի արժանի գնահատականը. Գագիկ Ծառուկյան  2.4 միլիոն դոլարը՝ դաստակին. Անանտ Ամբանին ցուցադրել է Շիվայի պատկերով ժամացույց՝ ադամանդներով և «Կնքահայրը» ֆիլմի երաժշտությամբ
2.4 միլիոն դոլարը՝ դաստակին. Անանտ Ամբանին ցուցադրել է Շիվայի պատկերով ժամացույց՝ ադամանդներով և «Կնքահայրը» ֆիլմի երաժշտությամբ Կոլումբիայում տեղի է ունեցել ահшբեկչական հшրձակում. զnհվել է 14 մարդ, վիրավnրվել՝ ավելի քան 38-ը
Կոլումբիայում տեղի է ունեցել ահшբեկչական հшրձակում. զnհվել է 14 մարդ, վիրավnրվել՝ ավելի քան 38-ը Թշնшմին ձգտում է հասարակական դժգոհություն առաջացնել ենթակառուցվածքների nչնչացման միջոցով․ Փեզեշքիան
Թշնшմին ձգտում է հասարակական դժգոհություն առաջացնել ենթակառուցվածքների nչնչացման միջոցով․ Փեզեշքիան Հորոսկոպ. Ինչպես որոշել մոլորակների ուժեղ և թույլ կողմերը ձեր ծննդյան քարտեզում
Հորոսկոպ. Ինչպես որոշել մոլորակների ուժեղ և թույլ կողմերը ձեր ծննդյան քարտեզում
 Այն մասին, թե ինչու է մեր ազգի պայքարը այսօր էլ շարունակվում, և ինչու թշնամու մորթապաշտ կամակատարները չեն կարող այն կասեցնել․ Ավետիք Չալաբյան
Այն մասին, թե ինչու է մեր ազգի պայքարը այսօր էլ շարունակվում, և ինչու թշնամու մորթապաշտ կամակատարները չեն կարող այն կասեցնել․ Ավետիք Չալաբյան Խնջույք՝ ժանտախտի օրերին․ այսօր ՔՊ-ի տոնն էր, ոչ թե՝ քաղաքացու․Սողոմոնյան
Խնջույք՝ ժանտախտի օրերին․ այսօր ՔՊ-ի տոնն էր, ոչ թե՝ քաղաքացու․Սողոմոնյան
 Քասախ գյուղում «VAZ» մակնիշի ավտոմեքենան բшխվել է գովազդային վահանակի սյանը․ կա վիրшվոր
Քասախ գյուղում «VAZ» մակնիշի ավտոմեքենան բшխվել է գովազդային վահանակի սյանը․ կա վիրшվոր «Ռեալը» վերջին վայրկյաններին բաց թողեց հաղթանակը
«Ռեալը» վերջին վայրկյաններին բաց թողեց հաղթանակը
 Չարենցավանում 41-ամյա վարորդը բեռնատար «Գազել»-ով դուրս է եկել ճանապարհի երթևեկելի գոտուց և բшխվել քարին․ կա վիրավnր
Չարենցավանում 41-ամյա վարորդը բեռնատար «Գազել»-ով դուրս է եկել ճանապարհի երթևեկելի գոտուց և բшխվել քարին․ կա վիրավnր Ադրբեջանի և Ուկրաինայի միջև ստորագրվել է 6 փաստաթուղթ
Ադրբեջանի և Ուկրաինայի միջև ստորագրվել է 6 փաստաթուղթ
 Գագիկ Ծառուկյանն ընդունել է Կիոկուշին կարատեի միջազգային ֆեդերացիայի նախագահին և Կիոկուշին համաշխարհային միության գլխավոր քարտուղարին (տեսանյութ)
Գագիկ Ծառուկյանն ընդունել է Կիոկուշին կարատեի միջազգային ֆեդերացիայի նախագահին և Կիոկուշին համաշխարհային միության գլխավոր քարտուղարին (տեսանյութ)
 Իսպանիայում մշակվել են երկչափ արևային վահանակներ, որոնք իդեալական են շենքերի ճակատների համար
Իսպանիայում մշակվել են երկչափ արևային վահանակներ, որոնք իդեալական են շենքերի ճակատների համար Հնդկաստանում էթնիկ խմբավորումների միջև փոխհրաձգություն է տեղի ունեցել. կա 3 զոհ
Հնդկաստանում էթնիկ խմբավորումների միջև փոխհրաձգություն է տեղի ունեցել. կա 3 զոհ
 Իսրայելական ԱԹՍ-ները hարվածել են Լիբանանի հարավին
Իսրայելական ԱԹՍ-ները hարվածել են Լիբանանի հարավին
 Զելենսկին առաջարկել Է Ուկրաինայի և Ռուսաստանի միջև բանակցություններ անցկացնել Ադրբեջանում
Զելենսկին առաջարկել Է Ուկրաինայի և Ռուսաստանի միջև բանակցություններ անցկացնել Ադրբեջանում Աճառյան փողոցում մեքենաներ են բախվել․ կան տուժածներ
Աճառյան փողոցում մեքենաներ են բախվել․ կան տուժածներ
 Մահացու որս. միլիոնատեր որսորդին փղերը ոտնակոխ են արել Աֆրիկայում՝ սաֆարիի ժամանակ
Մահացու որս. միլիոնատեր որսորդին փղերը ոտնակոխ են արել Աֆրիկայում՝ սաֆարիի ժամանակ Նյու Յորքի քաղաքապետի հայտարարությունը և Ադրբեջանի ԱԳՆ-ի դատապարտումը. Էդմոն Մարուքյան
Նյու Յորքի քաղաքապետի հայտարարությունը և Ադրբեջանի ԱԳՆ-ի դատապարտումը. Էդմոն Մարուքյան Լա Լիգա․ Լամին Յամալն՝ ամսվա լավագույն խաղացող
Լա Լիգա․ Լամին Յամալն՝ ամսվա լավագույն խաղացող
 Այս օրը հիշվելու է որպես խաբված քաղաքացու օր. Ալիկ Ալեքսանյան
Այս օրը հիշվելու է որպես խաբված քաղաքացու օր. Ալիկ Ալեքսանյան Արդեն ոչ ոք չի կարող Վաշինգտոնին լիարժեք գնահատել որպես դաշնակից․ Մակրոն
Արդեն ոչ ոք չի կարող Վաշինգտոնին լիարժեք գնահատել որպես դաշնակից․ Մակրոն
 Փողը, թե՞ գաղափարը․ ի՞նչն է իրականում ձևավորում ընտրությունների արդյունքը․ Էդմոն Մարուքյան
Փողը, թե՞ գաղափարը․ ի՞նչն է իրականում ձևավորում ընտրությունների արդյունքը․ Էդմոն Մարուքյան Tesla-ն թողարկել է սերիական էլեկտրական մեքենան՝ Cybercab
Tesla-ն թողարկել է սերիական էլեկտրական մեքենան՝ Cybercab
 Ահա, թե ինչպես են «լվանում» ցեղասպանին և մանիպուլացնում ժողովրդին․ Էդմոն Մարուքյան
Ահա, թե ինչպես են «լվանում» ցեղասպանին և մանիպուլացնում ժողովրդին․ Էդմոն Մարուքյան Գոհար Ավետիսյանը կիսվել է նոր ֆոտոշարքով
Գոհար Ավետիսյանը կիսվել է նոր ֆոտոշարքով
 «Նրանք ուժեղ են». «Արարատ-Արմենիա-2013»-ի պատանի ֆուտբոլիստները Սոչիում արծաթե մեդալ նվաճեցին (Տեսանյութ)
«Նրանք ուժեղ են». «Արարատ-Արմենիա-2013»-ի պատանի ֆուտբոլիստները Սոչիում արծաթե մեդալ նվաճեցին (Տեսանյութ) Մեր դեմ բաց պшտերազմ է հայտարարվել․ Լավրով
Մեր դեմ բաց պшտերազմ է հայտարարվել․ Լավրով
 Եթե Իրանի հետ համաձայնագիրը հաջող լինի, մենք պատրաստ ենք աստիճանաբար մեղմացնել պատժшմիջոցները․ Մերց
Եթե Իրանի հետ համաձայնագիրը հաջող լինի, մենք պատրաստ ենք աստիճանաբար մեղմացնել պատժшմիջոցները․ Մերց ԵՄ-ն կորցրել է 25 միլիարդ եվրո՝ ԱՄՆ-իսրայելական զինվшծ ուժերի և Իրանի միջև պшտերազմի պատճառով․ Ուրսուլա ֆոն դեր Լայեն
ԵՄ-ն կորցրել է 25 միլիարդ եվրո՝ ԱՄՆ-իսրայելական զինվшծ ուժերի և Իրանի միջև պшտերազմի պատճառով․ Ուրսուլա ֆոն դեր Լայեն Ուժեղ Հայաստան» կուսակցության անդամ Գոհար Ղումաշյանը տեսանյութ է հրապարակել Սամվել Կարապետյանի հետ թիմի հանդիպումից
Ուժեղ Հայաստան» կուսակցության անդամ Գոհար Ղումաշյանը տեսանյութ է հրապարակել Սամվել Կարապետյանի հետ թիմի հանդիպումից Զրույց Պահեստազորի սպաների միության ներկայացուցիչների հետ՝ հույսի, միասնության և այն փոփոխությունների մասին, որ Սամվել Կարապետյանն է բերելու. Նարեկ Կարապետյան
Զրույց Պահեստազորի սպաների միության ներկայացուցիչների հետ՝ հույսի, միասնության և այն փոփոխությունների մասին, որ Սամվել Կարապետյանն է բերելու. Նարեկ Կարապետյան Ամեն ինչը փաստերով կներկայացվի մայիսին․ Արշակ Կարապետյան
Ամեն ինչը փաստերով կներկայացվի մայիսին․ Արշակ Կարապետյան Ցեղասպանությունն ուրանում են, բայց հունիսի 7-ին քաղաքացին կկանխի դա. Շարմազանով
Ցեղասպանությունն ուրանում են, բայց հունիսի 7-ին քաղաքացին կկանխի դա. Շարմազանով
 Իշխանությունը մաքրում է ցեղասպան թուրքի անունը. Էդմոն Մարուքյան
Իշխանությունը մաքրում է ցեղասպան թուրքի անունը. Էդմոն Մարուքյան Եթե այս իշխանությունը մնա, թոշակի անցնելու տարիքը բարձրանալու է․ Հրայր Կամենդատյան
Եթե այս իշխանությունը մնա, թոշակի անցնելու տարիքը բարձրանալու է․ Հրայր Կամենդատյան Հայաստանի 1000 խոշորագույն հարկատուները․ ովքեր են առաջատարները
Հայաստանի 1000 խոշորագույն հարկատուները․ ովքեր են առաջատարները

 Այն մասին, թե ինչու է մեր ազգի պայքարը այսօր էլ շարունակվում, և ինչու թշնամու մորթապաշտ կամակատարները չեն կարող այն կասեցնել․ Ավետիք Չալաբյան
Այն մասին, թե ինչու է մեր ազգի պայքարը այսօր էլ շարունակվում, և ինչու թշնամու մորթապաշտ կամակատարները չեն կարող այն կասեցնել․ Ավետիք Չալաբյան
 Իշխանությունը մաքրում է ցեղասպան թուրքի անունը. Էդմոն Մարուքյան
Իշխանությունը մաքրում է ցեղասպան թուրքի անունը. Էդմոն Մարուքյան
 Ի՞նչ ուղերձ է փորձում փոխանցել մեր ժողովրդին Հայաստանի հանրային հեռուստաընկերությունը. Էդմոն Մարուքյան
Ի՞նչ ուղերձ է փորձում փոխանցել մեր ժողովրդին Հայաստանի հանրային հեռուստաընկերությունը. Էդմոն Մարուքյան
 Մեր պարտքն է ամեն օր ներդնել մեր ուժն ու հնարավորությունները, որպեսզի ապագա սերունդներին փոխանցենք ավելի բարեկեցիկ և կայուն հայրենիք. Գ. Ծառուկյան
Մեր պարտքն է ամեն օր ներդնել մեր ուժն ու հնարավորությունները, որպեսզի ապագա սերունդներին փոխանցենք ավելի բարեկեցիկ և կայուն հայրենիք. Գ. Ծառուկյան
 «ՀայաՔվեի» համակարգող Ավետիք Չալաբյանի հարցազրույցը Եվրախորհրդարանում
«ՀայաՔվեի» համակարգող Ավետիք Չալաբյանի հարցազրույցը Եվրախորհրդարանում
 Շնորհավոր տոնդ, սիրելի՛ հարկ վճարող
1
Շնորհավոր տոնդ, սիրելի՛ հարկ վճարող
1
 Ջահերով երթը որպես քաղաքական ազդակ՝ հիշողության և ընտրության միջև
2
Ջահերով երթը որպես քաղաքական ազդակ՝ հիշողության և ընտրության միջև
2
 Ռոբերտ Ամստերդամը պահանջում է հետ վերցնել ԱՄՆ սենատորների նամակները, որոնք ուղղված են հայ ընդդիմադիր...3
Ռոբերտ Ամստերդամը պահանջում է հետ վերցնել ԱՄՆ սենատորների նամակները, որոնք ուղղված են հայ ընդդիմադիր...3
 Բելլա Բաբախանյանը ահազանգում է՝ ադրբեջանցիները հայ հոգևորականների սքեմը հագել, ծաղրում են ցեղասպանվա...4
Բելլա Բաբախանյանը ահազանգում է՝ ադրբեջանցիները հայ հոգևորականների սքեմը հագել, ծաղրում են ցեղասպանվա...4
Երբ քաղաքական դաշտը փոխվում է․ «Ուժեղ Հայաստան»-ի աճը և իշխանության անհանգստությունը
5
Երբ քաղաքական դաշտը փոխվում է․ «Ուժեղ Հայաստան»-ի աճը և իշխանության անհանգստությունը
5



